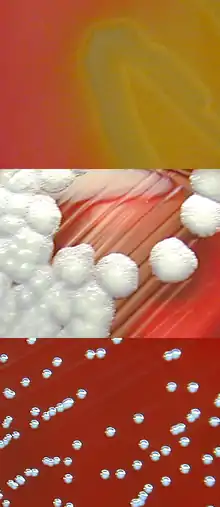

Гемоліз (мікробіологія)
Гемоліз — процес, що використовується для емпіричного ототожнення мікроорганізмів, заснований на здатності бактеріальних колоній на чашці Петрі з агаром руйнувати червоні кров'яні тільця. Цей метод має особливу важливість для класифікації видів роду Streptococcus. Речовина, яка звичайно зумовлює гемоліз — гемолізин. Хоча чашка Петрі («кров'яний агар») може містити різні концентрації червоних кров'яних тілець з різних тварин, більшість клінічних результатів повідомлюються для 5-10 % крові вівці (SBAP).
Приклади альфи (верх), бета (середина), і гамма (низ) гемолізу на чашці Петрі з агаром крові вівці
Типи гемолізу
- Альфа-гемоліз (α-гемоліз) присутній, якщо є зеленувате затемнення агару біля колоній бактерій і під ними. Streptococcus pneumoniae зумовлює альфа-гемоліз. Також інколи називається «зеленим гемолізом», через кольорову зміну в агарі. Інші синонімічні терміни — «неповний гемоліз» і «частковий гемоліз». Альфа-гемоліз загалом спричиняється перекисом водню, що виробляється бактеріями.
- Бета-гемоліз (β-гемоліз) зумовлює повний розпад червоних кров'яних тілець. Ділянки навколо і під колоніями освітлені й прозорі. Streptococcus pyogenes, або бета-гемолітичний стрептокок групи A, проявляє бета-гемоліз. Бета-гемоліз також називається «повним гемолізом» і спричиняється гемолізином.
- Деякі слабкі бето-гемолітичні види породжують інтенсивний бета-гемоліз, якщо вирощуються разом зі штамом Staphylococcus. Це називається «CAMP-тестом» (від імен R. Christie, N. E. Atkins та E. Munch-Peterson.). Streptococcus agalactiae та Clostridium perfringens проявляють цю властивість і можуть бути визначеними за цим тестом.
- Якщо мікроб не спричиняє гемоліз, говорять, що він показує гамма-гемоліз (γ-гемоліз): агар під і навколо колонії незмінний (такі організми називаються не-гемолітичними). Enterococcus faecalis (раніще відомий як Стрептокок групи D) показує гамма-гемоліз.
Посилання
- Ryan KJ; Ray CG (editors) (2004). Sherris Medical Microbiology (вид. 4th ed.). McGraw Hill. ISBN 0-8385-8529-9.
- ГЕМОЛІЗ ЕРИТРОЦИТІВ
- Іонов І.А., Комісова Т.Є., Слюсарєв В.Ф., Шаповалов С.О. Фізіологія крові та внутрішнього середовища: методичні рекомендації/Х.: ЧП Петров.- 2017.- 48 с. (С.17) Ел.джерело
This article is issued from Wikipedia. The text is licensed under Creative Commons - Attribution - Sharealike. Additional terms may apply for the media files.